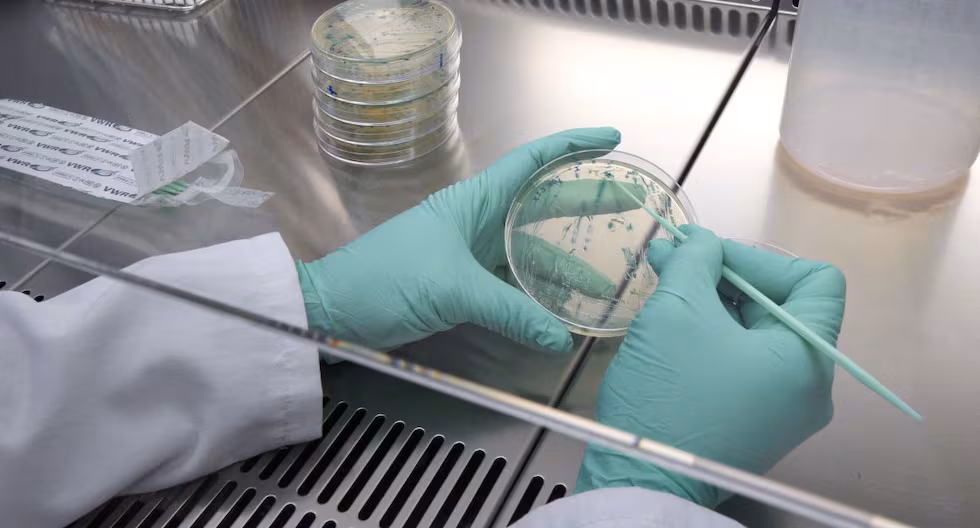

Google ha lanzado la beta 4 del sistema operativo Android 17 para los dispositivos de la gama Pixel, la última programada antes de su lanzamiento general, y en la que se menciona por primera vez la función ‘Pixel Glow’.
Google ha lanzado la beta 4 del sistema operativo Android 17 para los dispositivos de la gama Pixel, la última programada antes de su lanzamiento general, y en la que se menciona por primera vez la función ‘Pixel Glow’.
La compañía desplegó el pasado mes de febrero la primera beta de Android 17, permitiendo por primera vez a los desarrolladores empezar a probar la compatibilidad de sus aplicaciones y a identificar problemas.
MIRA: Artemis II: ¿la hazaña de volver a la Luna puede ser una oportunidad para el puerto espacial peruano?
En línea con esta misión, Google ha enfocado esta última beta a perfilar los detalles antes del lanzamiento global del sistema operativo. “La beta 4 te proporciona el entorno casi final que necesitas para realizar pruebas”, ha indicado el ingeniero de Relaciones con Desarrolladores, Dan Galpin, en el blog de desarrolladores de Android.
Concretamente, la beta 4 de Android 17 exige a los desarrolladores el cumplimiento de las restricciones de orientación, redimensionamiento y relación de aspecto en pantallas grandes; la extensión de la protección de Carga Dinámica de Código Segura (DCL) a las bibliotecas nativas; la habilitación por defecto de la transparencia de certificados (CT); protecciones de red local; y el refuerzo del audio en segundo plano.
Además, Android ha introducido los límites de memoria para las aplicaciones basados en la RAM total del dispositivo, para crear un entorno “más estable y predecible” y así evitar que las aplicaciones que consuman más recursos afecten al rendimiento global del sistema.
Pixel Glow
Más allá de estas novedades, la beta 4 de Android 17 alberga en su código una referencia sobre una herramienta llamada ‘Pixel Glow’, una evolución de las “animaciones de luz” de la fase 2 de la beta, descubierta por el equipo de Android Authority.
Bajo la premisa “disfruta el momento sin perder el contacto”, Google ha indicado en la beta que ‘Pixel Glow’ emite luces y colores “sutiles” en la parte trasera del dispositivo para notificar a los usuarios de actividades importantes cuando se encuentra boca abajo.
Según ha indicado el portal especializado 9to5Google, esta función se activara al interactuar con Gemini además de iluminar el dispositivo cuando se reciben llamadas o notificaciones de los contactos marcados como favoritos.

Deja una respuesta